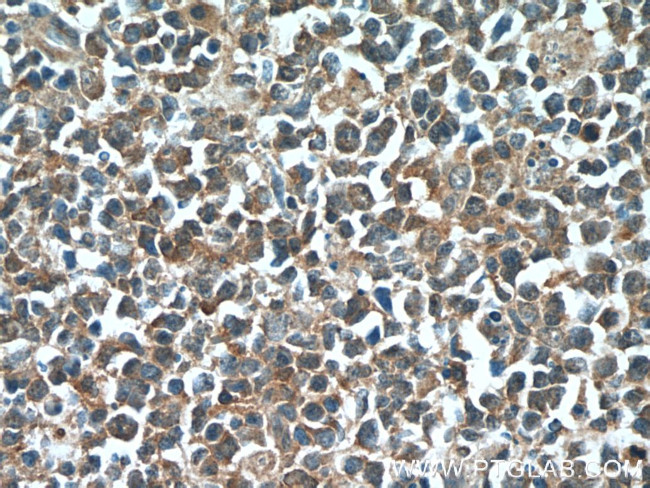
IRF7 Antibody in Immunohistochemistry (Paraffin) (IHC (P))

Search
Proteintech
IRF7 Polyclonal Antibody
{{$productOrderCtrl.translations['antibody.pdp.commerceCard.promotion.promotions']}}
{{$productOrderCtrl.translations['antibody.pdp.commerceCard.promotion.viewpromo']}}
{{$productOrderCtrl.translations['antibody.pdp.commerceCard.promotion.promocode']}}: {{promo.promoCode}} {{promo.promoTitle}} {{promo.promoDescription}}. {{$productOrderCtrl.translations['antibody.pdp.commerceCard.promotion.learnmore']}}
产品信息
22392-1-AP
种属反应
已发表种属
宿主/亚型
分类
类型
抗原
偶联物
形式
浓度
规格
纯化类型
保存液
内含物
保存条件
运输条件
产品详细信息
This antibody is a rabbit polyclonal antibody raised against the C-terminal 349 amino acid residues of human IRF7 D. The molecular weight of non-phosphorylated IRF7 is 44 kDa while phosphorylated IRF7 is 80-90 kDa.
Immunogen sequence: PGPFLAHTH AGLQAPGPLP APAGDKGDLL LQAVQQSCLA DHLLTASWGA DPVPTKAPGE GQEGLPLTGA CAGGPGLPAG ELYGWAVETT PSPGPQPAAL TTGEAAAPES PHQAEPYLSP SPSACTAVQE PSPGALDVTI MYKGRTVLQK VVGHPSCTFL YGPPDPAVRA TDPQQVAFPS PAELPDQKQL RYTEELLRHV APGLHLELRG PQLWARRMGK CKVYWEVGGP PGSASPSTPA CLLPRNCDTP IFDFRVFFQE LVEFRARQRR GSPRYTIYLG FGQDLSAGRP KEKSLVLVKL EPWLCRVHLE GTQREGVSSL DSSSLSLCLS SANSLYDDIE CFLMELEQPA (168-516 aa encoded by BC136555)
靶标信息
Interferons (IFNs) are involved in a multitude of immune interactions during viral infections and play a major role in both the induction and regulation of innate and adaptive antiviral mechanisms. During infection, host-virus interactions signal downstream molecules such as transcription factors such as IFN regulatory factor-3 (IRF3) which can act to stimulate transcription of IFN-a/b genes. IRF7 has been shown to play a role in the transcriptional activation of virus-inducible cellular genes, including interferon beta chain genes. IRF7 play a major role in the innate immune pathway, interacting with the Toll-like receptor (TLR) adaptor proteins MyD88 and Tirp/TRAM and functioning as an intermediate TLR4 and TLR9 signaling. There are at least four differentially spliced isoforms of IRF7, although their function has not been clearly established.
仅用于科研。不用于诊断过程。未经明确授权不得转售。
生物信息学
蛋白别名: Interferon regulatory factor 7; interferon regulatory factor-7H; IRF-7; IRF-7H; unnamed protein product
基因别名: IMD39; IRF-7; IRF-7H; IRF7; IRF7A; IRF7B; IRF7C; IRF7H
UniProt ID: (Human) Q92985, (Mouse) P70434
Entrez Gene ID: (Human) 3665, (Mouse) 54123